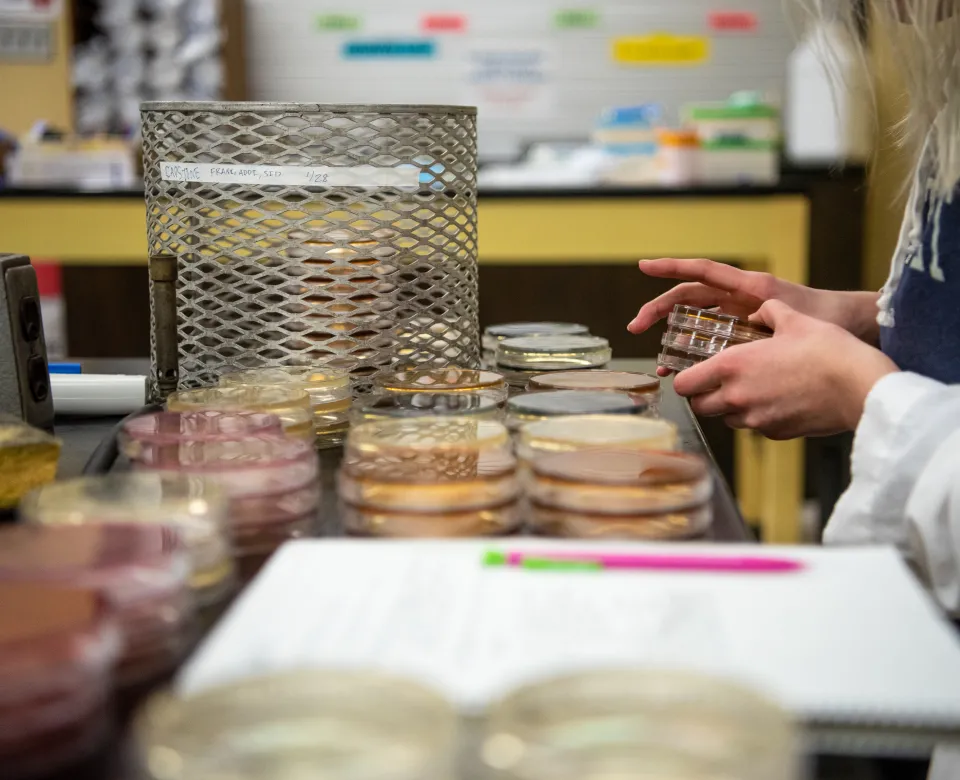
Student working with Petri dishes.

Exceptional Biological Research
The Department of Biological Sciences has an overarching research emphasis of “Environmental Adaptation: From Mechanisms to Evolutionary and Ecological Function”, which is approached from proximate mechanisms to ultimate consequences for evolutionary and ecological change. We have faculty with expertise in cell and molecular biology, as well as organismal and population biology. In addition, the local environment includes a diversity of climates as well as natural and human-influenced ecosystems, ranging from simple cropland monocultures to complex natural prairie ecosystems. This departmental research emphasis on environmental adaptation aligns nicely with emerging national initiatives, such as the National Ecological Observatory Network (NEON) as well as other assets in the region, such as the USGS Northern Prairie Wildlife Research Center in Jamestown, ND.
Within the general theme of environmental adaptation, the department has developed a focus on research related to biological timing. Changes in the timing of an organism’s life cycle events such as migration, reproduction, and flowering have wide implications for food systems, ecosystem services, and the resilience of natural communities, especially in light of climate change. Investigations in biological timing tie together the fields of genetics, genomics, molecular biology, ecology and evolutionary biology.
Discipline-Based Education Research
Another major research theme within the Department of Biological Sciences is discipline-based education research (DBER) at the undergraduate level. Coupling three DBER faculty in the Department of Biological Sciences with additional DBER researchers in Physics, Mathematics, and Engineering, a strong collaborative effort at NDSU is aimed at better understanding the nature of student learning within and across STEM (Science, Technology, Engineering, and Mathematics) disciplines. This research contributes to growing knowledge in several areas, including quantitative reasoning, visual thinking, scientific reasoning and metacognition.
Faculty Research
Plant Evolutionary Ecology - Steve Travers
Physiological Ecology, Seasonality, Biological Rhythms - Timothy Greives
Physiological Ecology - Britt Heidinger
Science Education - Jennifer Momsen
Science Education (emphasis in post-secondary science classrooms) - Lisa Montplaisir
Wetland Ecology, Biogeochemistry, Ecophysiology and Ecotoxicology - Marinus Otte
Behavioral and Evolutionary Ecology - Ned A. Dochtermann
Behavioral Ecology of Mammals (emphasis on bats) - Erin Gillam
Cell Cycle Regulation and Cell Motility in Cancer - Katie Reindl
Evolutionary and Developmental Biology - Julia Bowsher
Evolutionary Ecology of Native and Rare Fishes - Craig Stockwell
Insect Physiology and Immunology - Kendra Greenlee
Equipment and Facilities
The Department of Biological Sciences occupies approximately 20,000 square feet of floor space in Stevens Hall for research and teaching. The NDSU Library has extensive holdings of journals, monographs, books, and other reference materials covering various fields in biology. The library offers full access to online catalogs and databases.
Faculty in the department have research programs ranging from molecular biology to ecosystem ecology and work with a wide variety of organisms (algae, lichens, angiosperms, invertebrates, and vertebrates). Modern equipment is available for conducting research in cell and molecular biology and field ecology and behavior. The department has access to a vascular plant herbarium with 240,000 specimens emphasizing Northern Great Plains flora, a lichen herbarium consisting of about 15,000 specimens with a worldwide representation of taxa, and a vertebrate collection with approximately 10,000 specimens.
The department offers access to a range of equipment and facilities necessary for laboratory research including greenhouses, animal rooms, growth chambers, tissue culture facilities, ultracentrifuges, spectrophotometers, electrophoresis, light microscopes, gas chromatography, GC-mass spectrometry, and high performance liquid chromatography. Facilities are available for protein and DNA sequencing; oligonucleotide synthesis; interactive laser cytometry; scanning transmission and electron microscopy, and confocal microscopy. The department also recently opened a facility for studying birds, bats and small mammals, known as the Baviary, at the Red River Zoo.
In addition, Cassell Woods is a natural research site owned by the Department of Biological Sciences and located less than five miles from campus. The approximately 30-acre woodland consists of a mixture of deciduous trees, shrubs and conifers.

